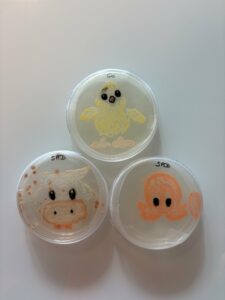

Journée Relais Exposciences 2025 à Decazeville
Le 8 décembre 2025, a eu lieu la Journée Relais Exposciences au Lycée La Découverte à Decazeville. Durant cette journée, des élèves de seconde, de première et de terminale STL et de BTS biotechnologie (première et deuxième année) ont pu échanger avec des professionnels dans le domaine de la biotechnologie. C’était une expérience enrichissante durant laquelle les élèves ont pu questionner les professionnels afin qu’ils aient des réponses concernant leur avenir et leur future orientation professionnelle.

Cet échange a été enregistré par Radio Francas, le podcast est disponible ici: https://audioblog.arteradio.com/blog/269414/journee-relais-exposcience-2025-lycee-la-decouverte
Les élèves ont également eu l’occasion de présenter les projets sur lesquels ils ont travaillé au cours de l’année : le projet Dépol Decaz, visant à sensibiliser sur la pollution, leur participation au concours annuel Agar’art, où ils ont créé des dessins à partir de micro-organismes ; ainsi que leurs travaux menés autour de la spiruline ou encore des microbiotes (bio-production et probiotiques).

Merci aux professionnels.les présents.es, à Stéphanie Mas pour l’organisation, au lycée la Découverte de Decazeville pour leur accueil et à Nicolas Renaud pour Radio Francas d’avoir animé l’échange.



